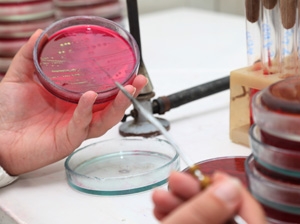

News Articles


California governor signs "right to die" bill
Date of Posting: 06-10-2015
California's governor has signed into law a bill that allows euthanasia for terminally ill patients, the fifth US state to do so. California has become the fifth US state to allow terminally ill patients to seek a doctor's help to end thei Read More...





Young Aussies not looking after their health and wellbeing
Date of Posting: 06-10-2015
Young Australian adults are less likely to do activities which would improve their mental health and wellbeing, a survey has found. Only 18 per cent of Australians regularly seek advice or support when they're feeling stressed or down.[subscri Read More...





Paracetamol beneficial for ICU patients
Date of Posting: 06-10-2015
Paracetamol helps some intensive care patients leave hospital quicker, new Australasian research indicates. Paracetamol is safe for treating patients in intensive care, helping many recover and leave hospital earlier, say Australasian researchers. Read More...





Codeine-related deaths on the rise
Last Updated: 05-10-2015
Almost half of codeine-related deaths in Australia from 2000 to 2013 are attributable to accidental overdose, say researchers. Deaths related to codeine, which soon could be available only on prescription, more than doubled in Australia between 20 Read More...





Genetic Test Identifies Which Early Stage Breast Cancer Patients Can Avoid Chemotherapy
Last Updated: 05-10-2015
The initial results of an international breast cancer clinical trial provides evidence that a genetic test is able to reliably identify a subgroup of women with early stage, hormone receptor positive breast cancer who can safely avoid chemotherapy. Read More...





More support needed for rural specialist services
Date of Posting: 05-10-2015
Action is needed to improve the stability of specialist medical services in rural Australia, say researchers. Only about half of medical specialists who provide outreach services to Australian rural communities visit the same town on a continuing Read More...





Breathing machine protects heart from radiation
Last Updated: 01-10-2015
A Brisbane hospital has become the first facility in Queensland to use a new technique to help improve radiation therapy for breast cancer sufferers. Queensland women battling breast cancer are now less likely to suffer harmful doses of radiation Read More...





Health Check: why do my muscles ache the day after exercise?
Last Updated: 29-09-2015
It’s normal to experience muscle pain after exercising if it’s been a while since you were active or performed a certain movement. This type of pain – called delayed onset muscle soreness or DOMS – generally develops severa Read More...





I'm not attacking doctors: Health Minister Ley
Last Updated: 29-09-2015
The federal government has promised it will have evidence before making any changes to taxpayer-funded medical procedures. Health Minister Sussan Ley insists she's not attacking doctors by asking Australians if they've undergone inefficien Read More...





New drug licensed for early breast cancer treatment
Last Updated: 29-09-2015
A new breast cancer treatment which could significantly lower death rates from the disease has now been licensed. A breast cancer drug that almost doubles the eradication of tumours and extends survival has been licensed for early stages of the di Read More...





1st stem cell eye op to cure macular degeneration
Date of Posting: 29-09-2015
A UK doctor has transferred embryonic stem cells to cure blindness in a patient suffering from age-related macular degeneration. A doctor in the UK has performed the world's first embryonic stem cell operation using a "patch" techniq Read More...





AMA supports powers to sedate ice addicts
Last Updated: 28-09-2015
The Australian Medical Association supports new guidelines allowing front-line emergency workers to subdue aggressive ice addicts. The Australian Medical Association has welcomed new powers for emergency doctors and nurses to subdue violent ice ad Read More...





Egg unboiler has big medical benefits
Last Updated: 28-09-2015
An Australian invention that can unboil an egg has been shown to have big medical benefits in being able to concoct a key anaesthetic in remote places. A device that won an Australian scientist an Ig Nobel award for uncooking an egg has now concoc Read More...





Aspirin increases life expectancy for gastro cancer patients
Last Updated: 28-09-2015
Once again, a review has found regular doses of small amounts of aspirin are beneficial - this time for gastrointestinal cancers. Aspirin can double the life expectancy of patients with cancers affecting the gastrointestinal tract, a major study h Read More...





Netball World Cup champion shoots for career goal
Last Updated: 25-09-2015
Students at the Careers Australia Adelaide campus came face to face with Australian World Cup-winning Netball Captain and Careers Australia Ambassador, Laura Geitz. Ms Geitz visited the Adelaide campus to speak to the students about their stu Read More...





Test may identify returning breast cancer
Date of Posting: 25-09-2015
In a significant development, researchers now believe they will be able to detect breast cancers likely to recur after treatment. A test may be in sight that can identify breast cancers most likely to return after treatment.[subscribe] Scientis Read More...





Taiwan suffers deadliest dengue outbreak in history
Last Updated: 25-09-2015
Taiwan is suffering its deadliest ever outbreak of mosquito-borne dengue fever with a record high of 42 deaths. Taiwan is suffering its deadliest ever outbreak of mosquito-borne dengue fever with a record high of 42 deaths, double the number that Read More...





Electrodes help paraplegic man walk again
Last Updated: 24-09-2015
Neurosurgeons have transmitted signals from a paraplegic man's brain to electrodes around his knees, allowing him to walk without using robotic limbs. A man confined to a wheelchair five years ago is able to walk again after scientists reconne Read More...





Breastfeeding doesn't improve IQ: study
Last Updated: 24-09-2015
A British study has found no reliable association between breastfeeding and higher IQ at age two. Breastfeeding does little to improve a child's intelligence, despite the widespread belief that "breast is best" for IQ, research has s Read More...





Longer wait needed before miscarry diagnosis
Last Updated: 24-09-2015
There is a risk healthy pregnancies could be ended because not enough time has passed between scans, experts say. Doctors should wait longer before diagnosing early miscarriage to avoid the risk of terminating healthy babies, UK experts have said. Read More...





Antibiotic alternative found for C. diff
Date of Posting: 24-09-2015
A drug that is being investigated for the treatment of arthritis and cancer, may also be able to treat a stubborn bacterial infection, a study suggests. A stubborn bacterial infection often acquired in hospitals and which can be deadly may have a Read More...

Warning over prescription painkillers
Date of Posting: 23-09-2015
Prescribed painkillers can have serious side effects if not taken as directed, says expert after overdose by footballers. Prescribed painkillers like oxycodone can be dangerous if not taken as directed, warns an expert.[subscribe] South Sydney Read More...





Dirty theatres, IT woes at Perth hospital
Last Updated: 23-09-2015
Operating theatres at Perth's new Fiona Stanley are sometimes left uncleaned, a parliamentary inquiry has been told. A parliamentary inquiry has heard of ongoing woes at Perth's new Fiona Stanley Hospital including unsanitary operating the Read More...





Physiotherapist misdiagnosis non-existent in emergency departments, according to new research
Last Updated: 23-09-2015
New research released by the Australian Physiotherapy Association (APA) has found that physiotherapists have displayed a 0% misdiagnosis rate in emergency departments across Australia. Released in conjunction with World Physiotherapy Day, taking p Read More...





Sex does not trigger heart attacks
Last Updated: 22-09-2015
A German study has found no evidence that sex can trigger a heart attack, even in people who have already suffered one. For those who want to grow old disgracefully, it could be good news.[subscribe] A study has found no evidence that sex can t Read More...





Qld Mum lobbies for Champix drug warning
Date of Posting: 21-09-2015
A mother has gathered almost 50,000 signatures calling on the federal government to mandate health warning labels on the anti-smoking drug, Champix. A Gold Coast mother whose son took his own life while taking the anti-smoking pills Champix is lob Read More...





Common coeliac test 'unreliable'
Date of Posting: 21-09-2015
Coeliac disease can only be definitevely diagnosed by a small bowel biopsy, says doctors warning against in-pharmacy tests In-pharmacy tests for coeliac disease are unreliable, say doctors.[subscribe] "Coeliac disease is a notoriously diff Read More...





Cancer survivor has 'miracle' baby
Last Updated: 17-09-2015
An Australian woman left infertile after cancer treatment has given birth to a 'miracle' daughter after an ovarian tissue graft and IVF. Baby Evie belongs to one of the most exclusive clubs in the world.[subscribe] Her Victorian mother, Read More...





Safety of antidepressant misreported: study
Date of Posting: 17-09-2015
A study claiming an antidepressant was safe for adolescents did not disclose data showing a link to suicidal or self-harming behaviours: new analysis An antidepressant was misrepresented as safe for adolescents, says new Australian-led research wh Read More...





Virtual nurse visits help young female cancer survivors
Date of Posting: 17-09-2015
Brisbane-based nurse Janine Porter-Steele will work face-to-face with young female cancer survivors across the country and she won't need to leave the office. QUT has developed and is now trialling the Younger Women's Wellness after Cancer Read More...





Lack of vitamin D speeds up mental decline
Date of Posting: 16-09-2015
Researchers have found that low levels of vitamin D doubled or even tripled the rate of cognitive decline in 382 men and women over the age of 60. Lack of vitamin D greatly accelerates the loss of mental ability that comes with age, a study has sh Read More...





Antibacterial soap not as effective as thought
Date of Posting: 16-09-2015
A new study has found there is "no significant difference" between the bactericidal effects of plain soap and antibacterial soap. Antibacterial hand soaps containing the chemical triclosan are not much better at killing germs than regula Read More...





Date of Posting: 14-09-2015
A new report card on Australia's sexual health is a mixed bag, with HIV infections stable but gonorrhoea and syphilis on the rise. The number of Australians contracting HIV has stabilised but about a thousand people a year are still returning Read More...





Push for Govt subsidies on new Hep C treatments
Date of Posting: 14-09-2015
The federal government is under pressure to immediately subsidise new Hep C treatments or risk the deaths of thousands more sufferers. Thousands more Australians could die from liver disease unless the government starts subsidising new Hepatitis C Read More...





Cancer survivors need to talk about sex
Last Updated: 11-09-2015
A cancer diagnosis takes a heavy toll on survivors' sex lives but there is something couples can do. Cancer survivors should be talking about sex if they want to get their intimate lives back on track.[subscribe] New research shows that the Read More...





Aussie men at higher risk of cancer death
Last Updated: 10-09-2015
The rate of US men dying from prostate cancer has fallen by 50 per cent in 17 years, compared with 25 per cent in Australia, research shows. Australian men have a higher chance of dying from prostate cancer than Americans and Canadians, a new stud Read More...





Vic prostate cancer research gets boost
Last Updated: 10-09-2015
The Victorian government has announced $1.6 million for prostate cancer research projects. Prostate cancer research funding has been given a boost as Victoria pushes to stop men dying young.[subscribe] Health Minister Jill Hennessy announced $1 Read More...





Seize the Day-Laughter in Oncology
Last Updated: 10-09-2015
I was interviewed for a research position coordinating a randomised controlled trial (RCT) in the oncology department of a leading metropolitan hospital. During the job interview the Chief Investigators, one of whom headed up the department, wanted t Read More...





Alzheimer's 'seeds' might be transferred through injection
Last Updated: 10-09-2015
Scientists are urging research into the risk of "accidental" medical transmission of Alzheimer's, after a study revealed several possible cases. People injected with hormones extracted from cadaver brains in a long-abandoned procedur Read More...





Traumatised servicemen helped by dogs
Last Updated: 10-09-2015
Traumatised former servicemen are being helped by dogs who comfort them, retrieve their medication and even turn on the lights. A dog turns on a light and a traumatised digger can now walk into the room.[subscribe] Another dog does the laundry, Read More...




